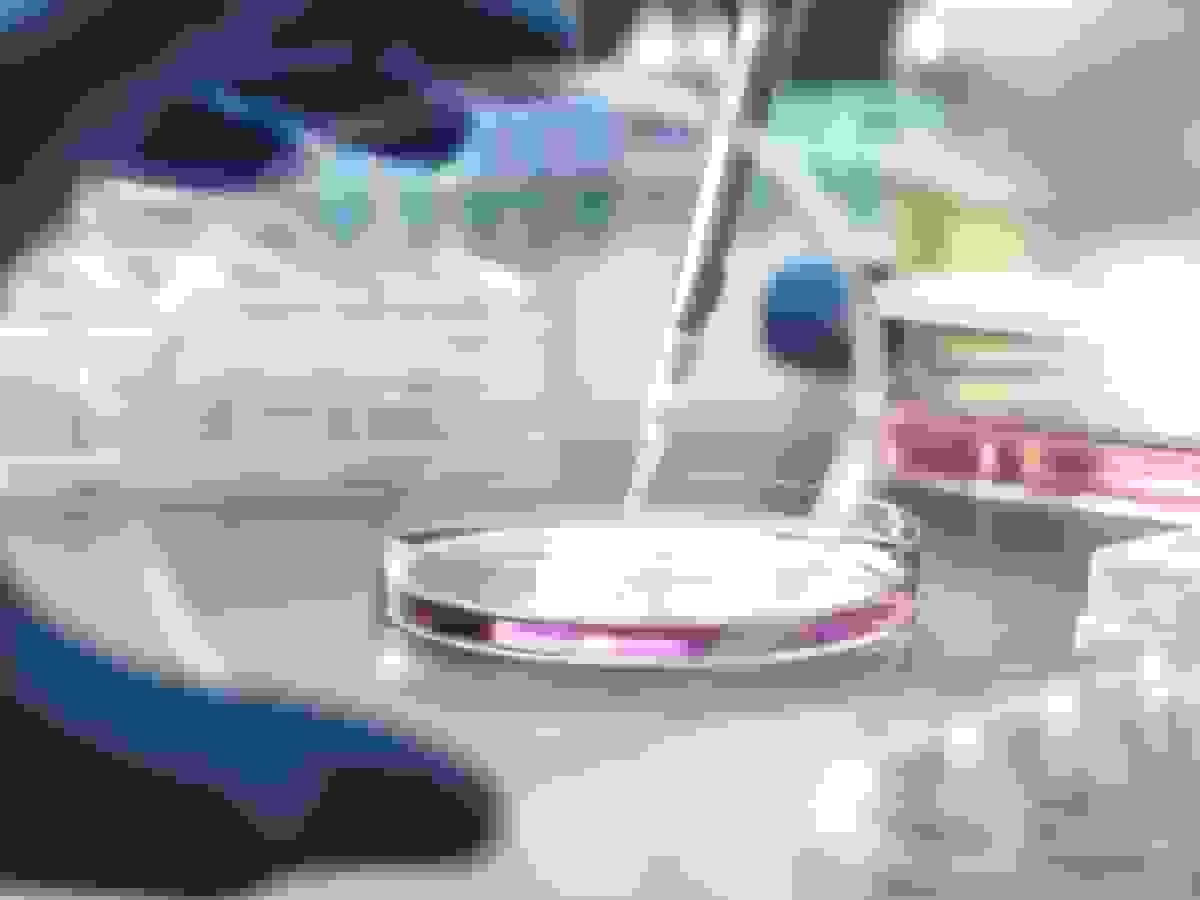
اس کی کپیتال در آستانه خرید شرکت سوئیسی توزیع دارو سوئییکس

نوسان سهام: لولو لیمون، کانوپی گروث و اوراکل (پادکست)
تحلیل روزانه برندگان و بازندگان بازار سهام توسط روزنامهنگاران بلومبرگ، شامل بررسی تغییرات سهام لولو لیمون، کانوپی گروث و اوراکل بر اساس اخبار شرکتها.

نوسان سهام: تحلیل بازار وال استریت
روزنامهنگاران بلومبرگ در این پادکست به تحلیل برندگان و بازندگان روز بازار سهام میپردازند. در این قسمت، تغییرات قابل توجه سهام سه شرکت مهم بررسی شده است:
- لولو لیمون (LULU): سهام این شرکت با رشد ۹.۶ درصدی همراه بود پس از اعلام کنارهگیری مدیرعامل، کالوین مکدونالد، پس از هفت سال. این تغییر نشاندهنده تحول احتمالی در استراتژی شرکت پس از کاهش فروش و افت بیش از ۶۰ درصدی سهام از اوج سال ۲۰۲۳ است.
- کانوپی گروث (CGC): سهام این تولیدکننده محصولات کانابیس با رشد خیره کننده ۵۳ درصدی روبرو شد. این صعود در پی انتظارات برای دستور دولت ترامپ به جهت بازطبقهبندی ماریجوآنا به عنوان مادهای با خطر کمتر رخ داد.
- اوراکل (ORCL): سهام این شرکت با کاهش ۴.۴۷ درصدی بسته شد. این افت پس از گزارش بلومبرگ درباره تأخیر در تکمیل مراکز دادهای که برای اوپنایآی ساخته میشوند، از ۲۰۲۷ به ۲۰۲۸، به دلیل کمبود نیروی کار و مواد، ایجاد شد.
"تأخیر در پروژههای اوراکل ناشی از کمبود نیروی کار و مواد است و تردیدها درباره اجرای آن را افزایش میدهد."
این تحلیلها بر اساس پوشش جامع بازار سهام آمریکا از طریق بلومبرگ تلویزیون، بلومبرگ رادیو و یوتیوب ارائه میشود.